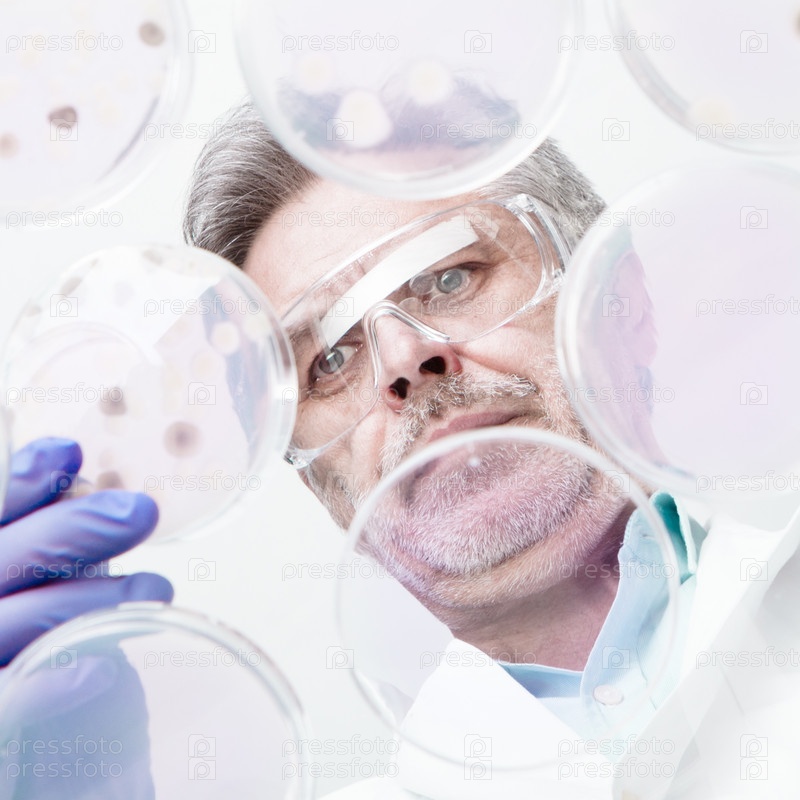

arrow_drop_down
Описание
Исследователь
Автор
ID файла
13214966
Формат файла
JPG
Максимальный размер
2400 x 2400 px, 300 dpi
Чашка ПетриБиохимикЛабораторная стеклянная посудаМедицинский образецКолбаМензуркаБиохимияПробиркаБактерияЛабораторная трубкаХимикЗащитные очкиМикробиологияТщательное изучениеМедицинский анализБиотехнологияХимическое веществоУчёныйЗащитная перчаткаТехникЛабораторный халатХимияНаучный экспериментЛабораторияМедицина и наукаОткрытиеПроверятьБиологияАнализироватьГигиенаМедицинский осмотрНаучно-исследовательская работаКонцентрацияВрачЛекарствоЖидкоcтьНаукаСтеклоКомпетентностьПрофессиональная деятельностьЗдравоохранение и медицинаРаботатьЛицо человекаОборудованиеДержатьСмотретьТехнологияПортретМужской полОдин человекМужчиныВзрослыйЕвропейского происхожденияЛюдиголубойчеловекжизньчеловеккрупный планблюдостаршийклеткапластинакультуранаукарастибиологическиймакротехнологиядетальздравоохранениеисследованиеанализироватьжидкийжидкостьочкимедицинаклиническиймедицинскийлабораторияобщийвирусиспытаниеаптеканаучныйбиологияэкспериментученыйисследовательобразецбиологическийтелоПетримикроскопическийбактерииколониягрибытрансплантатсывороткагенетикагенэболазикастекло
Ключевые слова
Мы также рекомендуем:
Зарегистрируйтесь, чтобы купить и скачать
это изображение в высоком разрешении.
это изображение в высоком разрешении.
Цены на
стандартную лицензиюarrow_drop_down
для
физлицarrow_drop_down
info_outlineПодписки info_outline
240 ₽
за скачивание одного изображения по подписке
2,400 ₽ в месяц
Пакеты изображений info_outline
600 ₽
за скачивание одного изображения штучно
1,200 ₽ за пакет
Зарегистрируйтесь, чтобы купить и скачать
это изображение в высоком разрешении.
это изображение в высоком разрешении.
Уже есть аккаунт? Войти

































































































